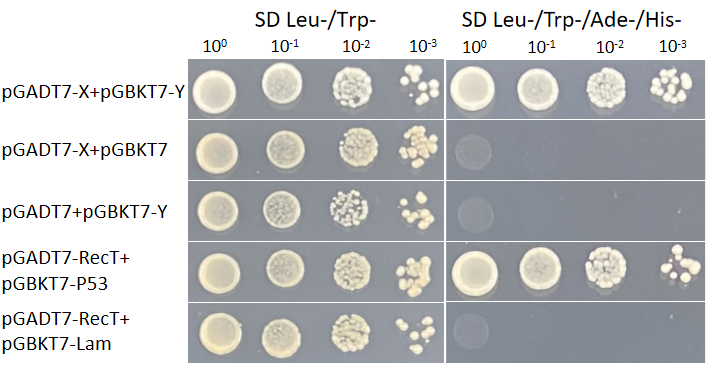

酵母双杂交一对一互作验证
- ZKSA-02
- 中科圣安
- 安徽省合肥市
- 定制协商
- 按需
- 议价
- 2024-01-15 10:35:05
安徽中科圣安生物技术有限公司


▲ 酵母双杂交原理示意图
酵母转录因子GAL4包括两个结构域,分别为DNA结合结构域(DNA-binding domain,BD)和转录激活结构域(Activating domain,AD)。BD能够识别位于GAL4-responsive gene的上游激活序列(Upstream activating sequence,UAS)并与之结合,AD可以启动UAS下游的基因进行转录。当BD或AD单独作用时不能激活转录,只有AD和BD在空间上充分接近时,GAL4转录因子才具有活性并激活下游基因的转录。
该技术利用酵母转录因子GAL4的特性,将AD与X蛋白融合,BD与Y蛋白融合,如果X、Y互作形成蛋白复合物,那么AD与BD会在空间上充分接近,使GAL4转录因子激活并启动报告基因的转录。
①AD与BD载体构建:目的基因克隆或目的基因合成;限制性内切酶酶切骨架载体并纯化;目的基因插入骨架载体;转化大肠杆菌,筛选阳性克隆并测序鉴定;
②共转酵母细胞:将目的AD载体与BD载体共同转化到酵母细胞中;
③二缺培养基培养转化的产物:将共转的酵母细胞均匀涂布在二缺板(SD/-Leu/-Trp)上培养;
④影印三缺和四缺板:将二缺平板上生长的酵母单克隆影印至三缺板(SD/-His/-Leu/-Trp)和四缺板(SD/-Ade/-His/-Leu/-Trp)上培养;
⑤拍照记录实验结果。

酵母双杂交实验流程图
技术服务范畴:验证两个已知蛋白质间的相互作用
技术服务优势:
①团队经验丰富;
②交付周期短,提供原始图片,保证数据真实可靠。
